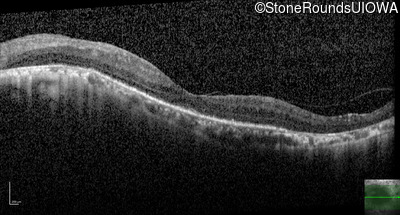

Case
SR2641
Student Mode
AR Retinitis Pigmentosa (IA1aiii)
Male
Male
Hidden
SR2641
Student Mode
AR Retinitis Pigmentosa (IA1aiii)
Male
Male
Highlighted Images
| Age at visit: 60 years | OD | OS |
|---|---|
History
This 60 year old man has had poor vision in dim light since about age 10. He lost vision in his right eye at about 16 due to toxoplasmosis. He has a mature cataract in the right eye with no view of the posterior pole. The retina in the right eye is attached by ultrasound.
| Age at visit: 60 years |
| OS | |||
|---|---|---|---|
| OS | |||
|---|---|---|---|
| OS | |||
|---|---|---|---|
Diagnosis & molecular findings
| Disease | Gene | Allele 1 variant(s) | Allele 2 variant(s) | Inheritance mode |
|---|---|---|---|---|
| AR Retinitis Pigmentosa | PDE6B | Pro496 del1gggC | His557Tyr CAC>TAC | AR |
Disease:
Gene:
Allele 1:
Pro496 del1gggC
Allele 2:
His557Tyr CAC>TAC
Inheritance:
AR